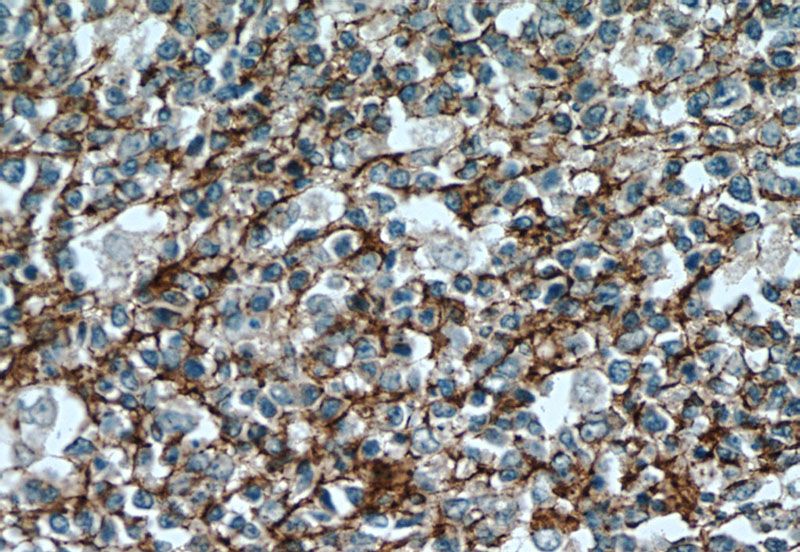
Immunohistochemical of paraffin-embedded human tonsillitis using Catalog No:109140(CD81 antibody) at dilution of 1:100 (under 40x lens)

-
Product Name
CD81 antibody
- Documents
-
Description
CD81 Rabbit Polyclonal antibody. Positive IHC detected in human tonsillitis tissue.
-
Tested applications
ELISA, IHC
-
Species reactivity
Human; other species not tested.
-
Alternative names
CD81 antibody; CD81 antigen antibody; CD81 molecule antibody; S5.7 antibody; TAPA1 antibody; Tetraspanin 28 antibody; Tspan 28 antibody; TSPAN28 antibody
-
Isotype
Rabbit IgG
-
Preparation
This antibody was obtained by immunization of CD81 recombinant protein (Accession Number: NM_004356). Purification method: Antigen affinity purified.
-
Clonality
Polyclonal
-
Formulation
PBS with 0.1% sodium azide and 50% glycerol pH 7.3.
-
Storage instructions
Store at -20℃. DO NOT ALIQUOT
-
Applications
Recommended Dilution:
IHC: 1:50-1:500
-
Validations

Immunohistochemical of paraffin-embedded human tonsillitis using Catalog No:109140(CD81 antibody) at dilution of 1:100 (under 10x lens)
Immunohistochemical of paraffin-embedded human tonsillitis using Catalog No:109140(CD81 antibody) at dilution of 1:100 (under 40x lens)
-
Background
CD81 (also known as TAPA1or TSPAN28) is a membrane protein of the tetraspanin superfamily, which are characterized by the presence of four conserved transmembrane regions. Many of these members are expressed on leukocytes and have been implicated in signal transduction, cell-cell interactions, and cellular activation and development. CD81 is involved in signal transduction and cell adhesion in the immune system (PMID: 9597125). CD81 has also been identified as en essential receptor for HCV (hepatitis C virus) (PMID: 21428934).
Related Products / Services
Please note: All products are "FOR RESEARCH USE ONLY AND ARE NOT INTENDED FOR DIAGNOSTIC OR THERAPEUTIC USE"
